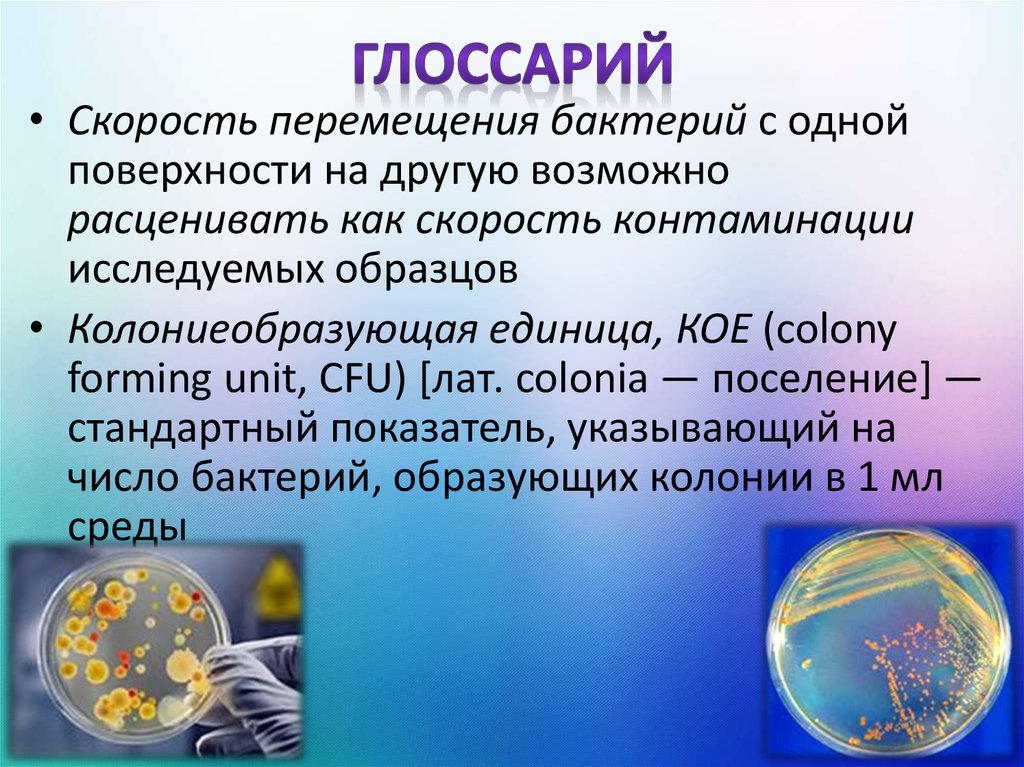
Глоссарий
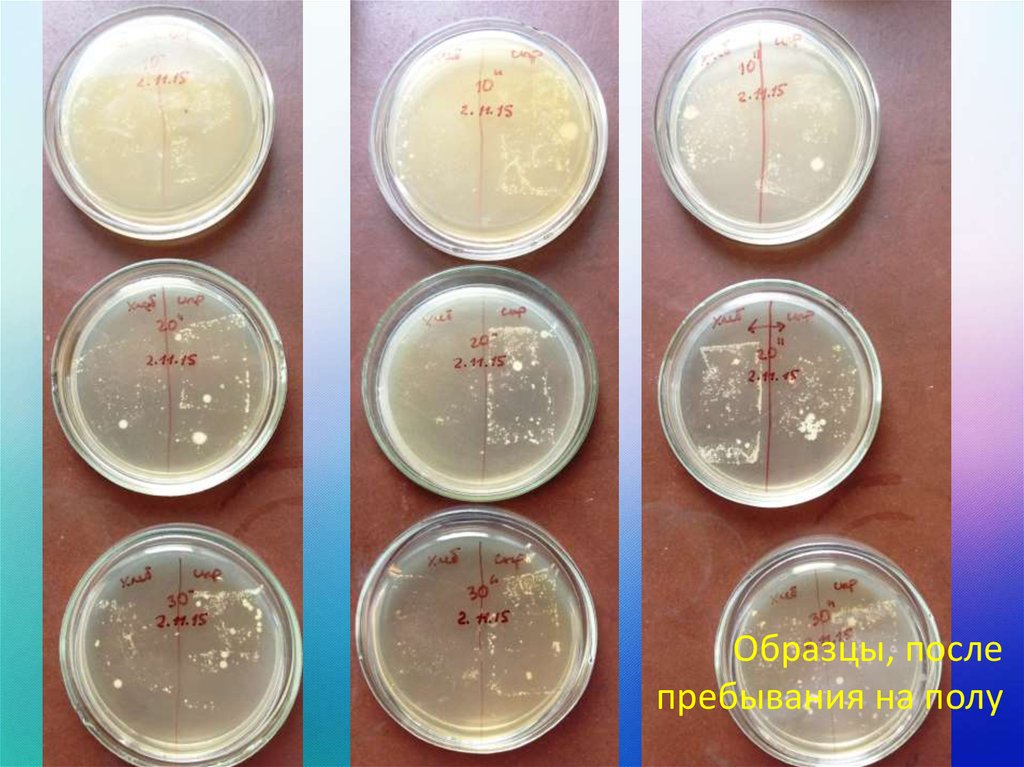

Похожие презентации:
Скорость перемещения бактерий с одной поверхности на другую
1. Задача № 6 Что упало – то пропало
2.
Если что-то съедобное уронить на пол иподнять меньше, чем через 30 секунд, то
этот продукт еще можно съесть
ПРАВДА
МИФ
3. Цели
• Подтвердить или опровергнуть даннуюгипотезу
• Рассчитать скорость контаминации
4. Глоссарий
• Скорость перемещения бактерий с однойповерхности на другую возможно
расценивать как скорость контаминации
исследуемых образцов
• Колониеобразующая единица, КОЕ (colony
forming unit, CFU) [лат. colonia — поселение] —
стандартный показатель, указывающий на
число бактерий, образующих колонии в 1 мл
среды
5.
• Способность бактерий к целенаправленномудвижению генетически обусловлена
• Монотрихи (род Vibrio) имеют на одном из
полюсов клетки только один жгутик
• Лофотрихи - пучок жгутиков (род
Pseudomonas)
• Амфитрихи – жгутики на обоих полюсах
клетки (род Spirillum),
• Перитрихи - по всей поверхности (род
Esherichia, Salmonella, Proteus, Bacillus)
6. Загрязнения напольного покрытия
Микрочастицы почвы
Споры бактерий
Химические вещества
Яйца гельминтов
7. Дизайн эксперимента
• Мазки-отпечатки на среду МПА:– Исходные образцы
– После пребывания на полу в течение 10 сек
– После пребывания на полу в течение 20 сек
– После пребывания на полу в течение 30 сек
МПА – универсальная среда для роста
бактерий. Специфические виды молочнокислых бактерий, присутствующих в данных
продуктах не дают роста в заданных условиях
эксперимента
8. Некоторые условия
• Эксперимент проводился с учетомсоблюдения гигиенических норм и правил
(мытье рук, влажная уборка)
• Напольное покрытие – линолеум
• Одинаковая площадь исследуемых
образцов
9.
10. Дизайн эксперимента
• Рост культуры в термостате (37±1 ºС)• Оценка результатов через 72 ч.
Исходные образцы
11.
Образцы, послепребывания на полу
12. Скорость контаминации в ряду опытов
87
6
5
4
ХЛЕБ КОЕ 10²
3
СЫР КОЕ 10²
2
1
0
исходный
образец
10 с
20 с
30 с
13. Бактериоскопическое исследование
• Исходные образцы хлебаГр+ бациллы
14. Бактериоскопическое исследование
• Образцы хлеба через 30 сГр+ бациллы
Гр+ кокки
15. Бактериоскопическое исследование
• Исходные образцы сыраГр+ кокки
16. Бактериоскопическое исследование
• Образцы сыра через 30 сГр+ бациллы
стрептобациллы
17. Выводы
• Утверждение о том, что за время, меньшее, чем 30сек. бактерии не достаточно для контаминации
продуктов является не соответствует полученным
результатам
• за 30 с количество КОЕ на хлебе возросло на 2,2*
10² КОЕ, на сыре – на 3,1 * 10² КОЕ, на сыре
• Принципиальным является конкретный состав
штаммов бактерий, присутствующих на полу
• Кроме того, после соприкосновения с полом на
продуктах могут оставаться частицы почвы, яйца
гельминтов, химические вещества
18. Используемая литература
Большая медицинская энциклопедия. Том 1/Главный редактор академик Б. В.
Петровский; издательство «Советская энциклопедия»; Москва, 1974.- 576 с.
Козлов Ю. А. Питательные среды в медицинской микробиологии, с. 62. М., 1950;
Руководство по микробиологической диагностике инфекционных болезней, под
ред. К. И. Матвеева, М., 1973: Тимаков В. Д. и Гольдфарб Д. М. Основы
экспериментальной медицинской бактериологии, с. 180, М., 1958.
Прозоркина Н.В.,Рубашкина Л.А. Основы микробиологии, вирусологии и
иммунологии. — Ростов-на-Дону:"Феникс", 2002. — С. 135.
Johnson ME, Lucey JA (April 2006). «Major technological advances and trends in
cheese». J. Dairy Sci. 89 (4): 1174–8. DOI:10.3168/jds.S0022-0302(06)72186-5. PMID
16537950.
http://meduniver.com/Medical/Microbiology/40.html
ГОСТ 26972-86 - Зерно, крупа, мука, толокно для продуктов детского питания.
Методы микробиологического анализа
ГОСТ Р 52972-2008. Сыры полутвердые. Технические условия
ГОСТ 30347-97. Молоко и молочные продукты. Методы определения
Staphylococcus aureus
ГОСТ Р 52814-2007. Продукты пищевые. Метод выявления бактерий рода
Salmonella

Медицина
Медицина








